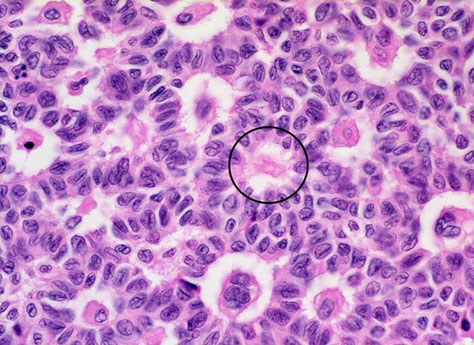

Ovary
Ovarian Embryology, Anatomy, Histology
(Pregnancy) Luteoma
Polycystic Ovarian Syndrome (PCOS)
Ovarian cysts
- Follicular cysts
- Corpus luteum cysts
- Theca-lutein cysts
- Chocolate cysts
Nodular hyperthecosis
Epitheial tumors
- Mucinous
- Mixed
- Serous
- Clear cell
- Brenner
- Endometrioid
Germ cell tumors
-
Teratoma
- Struma ovarii
- Endodermal sinus (yolk sac) tumor
- Dysgerminoma
- Choriocarcinoma
Stromal (sex cord) tumors
- Fibroma
- Granulosa / Theca cell
-
Sertoli-Leydig cell
- Tubular androblastoma (pure Sertoli cell tumor)
Gonadoblastoma
Pulmonary-type Small Cell Carcinoma
Sex cord tumor with annular tubules (SCTAT)
Mneumonic for types of ovarian tumors:
Ovaries make EGgS
- Epithelial
- Germ cell
- Stromal
Epithelial tumors:
Mucinous, Mixed, Serous, Clear cell, Brenner, Endometrioid
*Mexican Med Students, Creepy Breast Exams
Germ cell tumors:
***TED Convention or C TED ***
Teratoma
Endodermal sinus (yolk sac) tumor
Dysgerminoma
Choriocarcinoma
Stromal (sex cord) tumors: ***SLim FiGure***
- Fibroma
- Granulosa / Theca cell tumor
- Sertoli-Leydig cell tumor
Salpinges
Adnexal Papillary Cystadenoma of Probable Mesonephric Origin (APMO)
Andenomatoid tumor of salpinges
Chlamydia
Follicular salpingitis
IUD changes
Salpingitis isthmica nodosa
Tubal Intraepithelial Carcinoma (TIC)
Ovarian Embryology, Anatomy, Histology
Embryology
At ~5 WGA Genital ridge formed from thickening of coelomic epithelium(mesothelium) along mesonephros.
- Continuous growth of this thickening leads to gonadal anlage
-- the yolk sac endoderm sends gonad some primordial germ cells
--- these oogonia undergo mitosis, reaching max and then 66% dying out, all before birth
- primary oocytes formed when oogonia undergo meiosis + arrest in meiotic prophase at ~12-15 WGA
- Cortex (w/ sheets of primitive germ cells and littler pregranulosa cells) found at ~7-9 WGA
- As soon as vascular supply from medulla achieved, pregranulosa cells [sex cords] encircle single germ cells, in what are called primordial follicles.
- Cortex begins folliculogenesis at ~14-20 WGA (starts inner, then moves to outer)
- Theca interna formed perinatally when preantral and antral follicles surrounded by mesenchymal cells
Anatomy
3 zones : Cortex, medulla, hilus
Follicular structures: cystic follicles, yellow corpora lutea, white corpora albicantia
Surface epithelium
Single, pseudostratified (cuboidal/columnar/flat) epithelium modified from peritoneal cells.
- very fragile and rarely seen
- may invaginate to Epithelial Inclusion Glands (EIG)
-- which may form Epithelial Inclusion Cysts (EIC)
-- Inc EIGs and EICs (EIGCs) w/ age
--- psammoma bodies in lumen/ adjacent stroma
--EIGCs may be indicator for malignancy [(+)- WT-1, E-cadherin, p53, CA125/19-9, CEA, hCG, MH99, PLA, etc.]
-- Endosalpingosis???
- Walthard nest: group of (uroepithelial) transitional cells commonly found in serosa or fallopian tube stroma (similarity to Brenner tumor?)
Stroma
- Difficult to differentiate border between cortex and medulla microscopically
- stroma inc postmenopause, get fibrotic, hyaline scars, and granulomas too
- synth tropocollagen (converted to collagen outside cell), androstenedione, T, DHEA
-- inc synth w/ hCG, gonotropins, and insulin
- Spindle-shaped, sparse cytoplasm, in whorls or storiform
-- inc # of lipid droplets w/age, use fat stain
- tunica albuginea of ovary different from testes (which has dense collagen and is acellular)
- Luteinized stromal cells: polygonal cells with abundant eosinophilic/clear cytoplasm, variable amt of fat, central round nucleus, and standout nucleolus
-- (+) inhibin, calretinin, melan-A, CD10
-- inc in preg/ postmenopause
- Enzymatically Active Stromal Cells (EASCs)
-- also inc w/ age
- Decidual cells: identical to eutopic decidua; can vary
-- like to surround vessels
-- progesterone causes decidual reaction
- SM inc in ovaries w/age
-- also seen with stromal hyperthecosis and sclerocystic ovaries, and surrounding other dz's/CA's
-Endometrial stromal cells (stromal endometriosis) in stroma even in absence of endometriosis
- may see Leydig cells with their Reinke crystals
- Neuroendocrine/APUD-type cells rare but there
-- argyrophilic and argentaffinic
Primordial follicles: primary oocyte, enveloped by 1-3 layers of cuboidal granulosa cells
-- oocyte has Balbiani's Vitelline Body (BVB), an eosinophilic, crescent-shaped zone, w/ hypolucent dot (the centrosome) surrounded by a clearing and then PAS-(+) zone (mitochondria)
- 400,000 in prophase at birth in cortex
-- dec from folliculogenesis (ovulated) and atresia (99.9% of all primordial follicles) thereafter
--- primordial follicles that undergo atresia leave no trace; atresia of later follicles form a corpus fibrosum (Skarr!). Assoc androgens w/ atresia
Primary follicle: distinguishable because granulosa cells become columnar
Secondary/ preantral follicle: granulosa cells do the mitosis thang and form 3-5 layers around oocyte.
- Granulosa layer ain got no reticulin or vessels
- Zona pellucida (eosinophilic, PAS-(+), acellular) begins to form around oocyte periphery
- Call-Exner bodies: white blobs amongst granulosa cells
-- PAS-(+), contain excess basal lamina
Tertiary/ antral/ vesicular follicle: stromal cells surrounding follicle start to organize into theca interna/externa; granulosa cells secrete booger-sugar into an antrum
Mature/Graafian follicle: oocyte surrounded by zona pellucida and granulosa cells on a peninsula (cumulus oophorus) that protrudes into antrum; thecae well developed
- Corona radiata: oocyte with zona pellucida and single layer of granulosa cells that breaks off to float in antrum
-- Immediately before being ovulated into the peritoneum, the oocyte enters telophase of meiosis 1
--- then completes w/ formation of the first polar body
-- this polar body expelled and oocyte stops at metaphase 2 until fertilization
Corpus Luteum of Menstruation: ~2 cm cystic center filled w/ hemorrhagic coag.
- composed of cells that are relatively larger than granulosa cells; polygonal shaped, and lots of pale-eosinophilic cytoplasm
- +vimentin, inhibin, and calretinin, little/no CK
- K cells: few; dark red, stellate-shaped; hyperchromatic/pyknotic nuclei
-cells of corpus luteum phagocytosed; corpus albicans forms
Corpus Luteum of Pregnancy
- Grossly larger than CLM, and bright yellow
- corpus luteum cyst > 3cm > cystic corpus luteum
- cavity begins dissolution mid-term, should be gone at term
- See white blobby vacuoles and also eosinophilic colloid/hyalin droplets inside granulosa cells that enlarge as pregnancy progresses
-- eosinophilic colloid/hyalin granules become calcifications
- Thecal cells become thinner as preg progresses
- placental hCG stimulates Progesterone production by granulosa-lutein cells for a few days. What stimulates P prod after that? A mystery... (though P made in massive amounts by placenta)
- also makes relaxin
Corpus Albicans - Skarr!
- (+) ceroid/ hemosiderin - laden macrophages
- dense collagen w/ some fibroblasts
Hilus cells: indistinguishable from male Leydig cells.
- have Reinke crystals (rod-shaped, eosinophilic, nonrefractile)
-- (+) Masson's trichrome (dark red), Fe hematoxylin (black)
--- may confuse w/ erythrocytes compressed against capillaries
- don't confuse hilar cells w/ adreno-cortical rests
Rete ovarii: similar to rete testes; network of irregular channels
- surrounded by spindle cell stroma (like in ovaries)
- Present prenatally, then disappear in kids, only to come back in puberty and onward
- can surround or lie w/in nerves and rete ovarii
- (+) inhibin, calretinin, melan-A
Normal Female Gonadal Function
At puberty, the hypothalamus begins to produce intermittent spikes of Gn-RH; these spikes are essential for normal pituitary function
- transient decline in estrogen causes a sharp surge in production of LH, leading to ovulation. As LH remains high, it stimulates the production of progesterone. If fertilization and implantation occurs, about 7 days later, production of the major hormone of pregnancy (human chorionic gonadotropin (HCG)), begins. HCG is similar in structure and function to LH and maintains production of progesterone. If fertilization does not occur, LH and progesterone levels fall and menstruation occurs.









(Pregnancy) Luteoma
Very rare, b9; nodules of luteinized cells c lots of red cytoplasm
- seen during pregnancy (possibly from inc hCG), usually in multiparous black women;
- 2/3 unilat, 50% are single (vs multiple), can see corpus luteum
Gross: soft yellow-orange nodules
Micro: well circumscribed, round mass c polygonal cells c lots of red cytoplasm and possibly a little lipid inclusion (theca-lutein)), can have some nucleoli and a little bit atypia, low (2-3/hpf) mits
IHC: (+) a-inhibin, ck's, vimentin, CD99
Tx: Regress after preg (no tx)
(Pregnancy) Luteoma

Polycystic Ovarian Syndrome (PCOS)
Inc LH -> Ovarian stromal stimulation -> androgen production -> inc E -> pituitary sensitivity to Luteinizing Releasing Factor (LRF) -> pulsatile release of LH from pituitary -> inc LH ... etc etc
Amenorrhea c large bilat cystic ovaries
- assoc c infertility, obesity, hirsutism and insulin release
- inc risk of endometrial ca
Labs: inc LH, dec FSH, inc T, inc E
Tx: weight loss, OCPs (dec LH release), spironolactone, clomiphene, metformin
Ovarian cysts
Follicular cysts
Unruptured graafian follicles distend and eventually burst, which can cause sudden pain
- may have 1 per month [thus physiologic??]
- assoc c inc E and endometrial hyperplasia
Tx: observe
Corpus luteum cysts
Usually single, <6 cm, caused by bleeding into corpus luteum (cyst contents are bloody) either during menses or after preg
- tend to disappear by themselves
- normal in preg [physiologic]
- may rupture and bleed in to peritoneum, and be misdiagnosed as an ectopic preg
Micro: covered by luteinized theca and granulosa cell layers
DDx: Ectopic preg
Tx: observe
Corpus luteum cysts

Theca-lutein cysts
Bilat / multiple; caused by gonadotropin stim
- assoc c chorioca and moles
Endometriosis
1/10 rich Western women that don't take OCPs; up to 1/4 laparotomies; aka hocolate cysts; aka endometrioma
- need 2 of 3 for dx: em glands, em stroma, or hemorrhage (hemosiderin)
Hemorrhage-filled cyst due to ovarian endometriosis
- varies based on stage of menses, grows with E stim
- looks chocolately from hemosiderin deposits
IHC: CD10 highlights em stroma
- molecular - trisomy 1 / 7, DNA aneuploidy if very atypical
Px: can turn into clear cell carcinoma and endometrioid adenocarcinoma, this transformation is assoc c ARID1A mutations
Endometriosis with glands, stroma and hemorrhage

Nodular hyperthecosis
Hyperplastic ovarian stroma c clusters of luteinized stromal cells, usually in 6-7th decades; where the luteinized cells make androgens and exhibit sx similar to PCOS, except have higher T levels and no/less cysts; usually ots are obese c virilization and insulin resistance
Micro: scattered nests of luteinized theca cells in ovarian stroma
Tx: possibly excision or leuprolide if not surgical candidate
Ovarian cancer
Type 1
Low-grade serous, low grade endometrioid, mucinous, and clear cell carcinoma (some of them)
B9, borderline, invasive
- can be large cystic masses, usually unilateral
- have KRAS, BRAF, and ARDIA mutations
-- BRCA1/2 and TP53 rare in these tumors
Type 2
HG serous, HG endometrioid, MMMT, undifferentiated CA, (some) clear cell
More aggressive,
Assoc c BRCA1/2, TP53 mutations
can be tubal origin
Epithelial tumors
- MCC of ovarian tumors (>90%)
- more likely to be b9 in adolescent pts (in which age group they are only about 20% of all ovarian tumors)
-- >90% of non-mucinous ovarian cas are PAX8+, whereas only ~1/2 of mucinous cas are PAX8+
Mucinous
Must be sampled more generously
- usually have some intestinal type of lining
Suspect primary tumor if unilateral (esp left side), larger
- suspect mets if bilateral, vascular involvement, more goblet cells, surface involvement (should take out the appendix)

Mucinous cystadenoma
Mucinous cystadenoma
Mucous-exuding epithelium lining multilocular cysts; MCC ovarian mucinous tumors (~4/5)
- can look like intestine
- 1/10 assoc c Brenner tumor / dermoid cyst (teratoma)
- should try to distinguish primary from metastatic: consider primary if larger, unilateral, and arising from internal location (metastatic if smaller, assoc c carcinomatosis, and attached to serosa)
Micro: multiple cysts and glands lined by simple non-stratified epithelium, similar to GI epithelial lining
- can have focal papillae
- adjacent areas can have stromal luteinization
Genes: 3/5 have KRAS mutation
Px: B9
Mucinous Borderline Tumor
- aka Atypical Proliferative Mucinous Tumor (APMT) or Low Malignant Potential (LMP)
2nd MCC borderline / atypical tumor
- 1/5 get pseudomyxoma ovarii
Micro: has multiple layers of cells (GI-type epithelium, goblet cells, NE cells, Paneth cells) c big dark nuclei
- tufting and slender villi more prominent
- does not have high-grade nuclear features
- prolif areas >10% of epithelial vol

Mixed gct c teratomatous component c resp (lt) and yolk sac tumor (Mod path, poulos)


Mucinous cystadenocarcinoma
can get pseudomyxoma peritonei (intraperitoneal accum of mucous from tumor), aka jelly belly
- can have back to back or expansile growth
-- expansile growth can have better px
IHC: (+) PAX8 (1/2 - see below);
- neg
-- >90% of non-mucinous ovarian cas are PAX8+, whereas only ~1/2 of mucinous cas are PAX8+
Mixed
isochromosome 12p (similar to etiology in testis) in mixed gct c teratomatous components
Serous tumors
Broken down into a type I and type II
- type I (low grade) has lots of mutations of KRAS and BRAF, but not of TP53
- type II (high grade) has TP53 mutations, almost always
- cell of origin is probably tubal epithelium that has undergone Mullerian metastatic changes
Serous cystadenoma
1/5 of ovarian tumors, usually bilat
- 70% of serous tumors
Gross: watery yellow clear cystic fluid, can be mucoid or more viscour, can have fuzzy excrescences on internal surface
Micro: lining of tall, ciliated fallopian-tube like epithelium in stroma c spindly fibroblasts, no atypia and no invasion into wall of cyst
- may have simple papillary structures
Px: B9

Serous Cystadenofibroma
Variable, c solid fibrous areas and knobby papillary areas
Adenofibroma
Completely solid appearing
Serous Borderline Tumor (Low Malignant Potential)
Tumor in young preg women
- type I tumor that has lots of KRAS and BRAF mutations but not TP53 mutations
Micro: to dx should see branching papillary fronds in exophytic growth pattern
- can have nuclear atypia, high mits, statification and branching papillary fronds
- however, must NOT have stromal invasion
Broad hierarchical Branching papillae
*** Broad Branching Borderline ***
- stratified atypical epithelium c occasional mits
- 1/10 have microinvasion, but these are usually not malignant
- stroma fibrous + edematous c variable psammoma bodies
IHC: (+) CAM5.2, EMA, BER-EP4, WT1, PAX8, high ER/PR, p53 wild type
- diffuse p16 absent
Genes: 1/2 have KRAS / BRAF mutations
Px: everyone lives if confined to ovary, but turns to 9/10 5 yr survival if goes to peritoneum
- rarely transforms into high-grade serous ca bc develops along different molecular pathway
Serous borderline tumor

Micropapillary pattern in a serous borderline tumor, looks like a medusa head

Serous cystadenocarcinoma
1/2 of ovarian tumors, frequently bilateral
Micro: psammoma bodies, back to back glands without any intervening stroma
Px: malig
Micropapillary serous carcinoma
Looks like a medusa head
- usually a low grade malignancy, can have implant which can be invasive
Serous ca graded into Low or HIgh grade based on nuclear features and mit index (Low grade has <12, high grade has >12 mits / 10 HPFs)
Low-grade Serous Carcinoma (LGSC)
~1/20 serous ca's, pts usually younger than those that get high-grade serous ca, usually bilateral, rarely has necrosis
Histo: usually not necrosis, cells can be mildly pleomorphic, frequent psammoma bodies, low mits (2-3/hpf)
IHC: (same as serous borderline), low Ki67, ER/PR (1/2)
- negative p53 staining
Genes: 1/2 have KRAS / BRAF mutations
Tx: not responsive to chemo
Px: excellent if confined to ovaries
- if have a mass >2 cm after surgery, poor outcome
High-grade Serous Carcinoma (HGSC)
MCC death from ovarian ca, dec risk if you have lots of kids (not as many menstrual cycles), in older females (7th decade)
- MCC ovarian ca (60-80%; endometrioid ca up to 20%, mucinous ca up to 15%, clear cell ac and urothelial ca much less)
Labs: inc CA125 (>500)
Histo: epithelial cells c papillary, glandular, and solid patterns, nuclei c lots of nuclear atypia and hyperchromasia, prominent red nucleoli, numerous atypical mits
- marked nuclear pleomorphism and nuclear size variation >3:1 c lots o mits (>12 / 10 hpf)
- also assoc c serous tubal intraepithelial carcinoma (STIC)
IHC: (+) WT1 (negative in endometrial serous ca, 2/2 mesothelial origin of cell?), strong (>60%) TP53 [p53 stain may also be completely negative if a missense mutation has occurred ["null phenotype"], must check controls!!], PAX8, CK7, B72.3, EMA
- neg PAX-2, CK20
Genes: assoc c P53 mutations
Tx: usually chemo
Px: usually are high stage at dx; stage is most important px factor
High-grade serous carcinoma


Clear cell adenofibroma
Very rare benign tumor c bland cuboidal to flat cells c clear to reddish cytoplasm in a fibrous stroma
Clear cell borderline tumor
Basically clear cell adenofibromas with glandular epithelial atypia, but no stromal invasion
- pretty rare (<1% of borderline / atypical tumors)
- MC in postmenopausal F in 7th decade; nearly always unilateral; ~ 6 cm size
Histo: glands are usually round (which do not invade as mentioned) and are lined by cells c clear to reddish cytoplasm that can be flat to cuboidal and hobnailing
- no/few mits
- usually see some areas of endometriosis
Genes: may have ARID1A, esp if found c areas of clear cell carcinoma, indicating some genetic relation
Px: usually b9


Clear cell carcinoma

Clear cell adenocarcinoma

Clear cell carcinoma
High grade tumor in women in 6th decade, arises from endometriosis in 7/10, unilateral, 15 cm avg
- assoc c Lynch syndrome and endometrioisis
- also assoc c hyper Ca2+ and VTE
- grossly solid and cystic
Histo: tubulocystic, papillary, and solid patterns
- round to polygonal clear cells that can look reddish
- hobnail cells common, c dark eccentric nuclei c large nucleoli
- mits uncommon
- can have psammoma bodies and eosinophilic hyaline bodies
IHC: (+) PAS [diastase sensitive], CK7, EMA, PAX8, HNF-1beta, napsin A
- negative WT1, CK20, TP53, CDKN2A, ER/PR
ARID1A (in 1/2, corresponds to BAF250a expression), PIK3CA (4/10), PTEN (1/10)
DDx: metastatic RCC (differentiate with CD10, HNF and napsin A
Px: dependent on stage
- poor response to platinum-based chemo in high-stage dz
Brenner tumor
Prolif that comes from surface epithelium (like Walthards nests), usually b9
Gross: uniform, hard white nodule
Micro: solid nests of urothelioid-cells (sharply outlined c pale cytoplasm, nucleoli, groovy nucleus) surrounded by fibrous tissue
- can be malig (or borderline)
-- if cannot see b9 Brenner component can look like transitional cell carcinoma
IHC: (+) CK7, thrombomodulin, uroplakin III
- negative CK20
Px: better than urothelial ca
Brenner tumor

Endometrioid carcinoma
Rare, in mid age females (50 yo), >10% occur c endometriosis (possible etiology??), also assoc c keratin granulomas of peritoneum
- up to 1/3 pts have endometrial hyperplasia / carcinoma
Gross: solid, cystic and hemorrhagic, 1/20 bilat, avg 11cm, no papillae
Micro: can have non-cystic villoglandular pattern, glandular confluence or stromal disappearance
- looks like endometrioid adenoca of endometrium
- stromal invasion is confluent glandular growth, stromal disappearance or clear-cut invasion of stroma
- 1/2 have squamous metaplasia
- rarely invades BVs
IHC: (+) ER/PR (highly expressed), keratins, CEA and HPL (variable), N-cadherin, EMA
- neg: sex-cord stromal markers (CD99, Inhibin, Calretinin, Melan-A), SYN, CHR, TTF-1, thyroglobulin
Genes: PTEN mutations (in 1/5)
Px: similar to serous, though usually present at lower stage than serous; not as good as borderline tumors
- must be well-sampled bc serous or undifferentiated ca lowers survival from 65% to <10% at 5 yrs
- very aggressive if has yolk sac component

Endometrioid AC

Germ cell tumors
- MCC ovarian tumor in younger adults / teens / adolescents (60% of all ovarian tumors in this age group, though ovarian tumors in younger pts are quite rare)
- combined c sex-cord stromal tumors, are about 5% of all ovarian neoplasms
- usually express some kind of hormone, which can be followed to assess for recurrence
- PLAP is strongly positive in all germ cell tumors
- germ cell tumors assoc c isochromosome 12
Teratoma
MCC ovarian germ cell tumor
- has mature cells from 2-3 of the germ cell layers, usually cystic and rarely solid
Dermoid Cyst (mature teratoma)
MCC b9 germ cell tumor
Immature teratoma
aggressive and malignant of children and adolescents, resembling embryonal or fetal tissue (can be tough to see if tissue is immature or not)
- must be appropriately staged
- assoc c yolk sac tumor (which can be overlooked if hepatoid elements present bc looks like normal fetal tissue), which is usually a sign that they will recur more often
- MC tissue component is neuronal
Gross: hemorrhage and necrosis, multiloculated and solid components
Micro: nerve, mesoderm, esophagus, liver, GI components found
- grade based on amount of immature nerve / neuroepithelium (neural tubules and rosettes)
Grade 1: <1 low power field of neuroepithelium
Grade 2: 1-3 " "
Grade 3: >3 " "
Tx: excision, chemo
Px: usually recur in a couple years
- may be better if recurs as only mature teratoma
Immature teratoma

Sacrococcygeal Immature Teratoma
Micro: variable amounts of mature and immature elements, including disordered arrangement of ectodermal, mesodermal, and endodermal tissues
- variable amounts of neuroectodermal tissue, mature cartilage, mature epithelial elements, and undifferentiated spindle cells
Gliomatosis peritonei
Mature glial implants in peritoneum, usually only a few millimeters in size
- seen in 1/4 cases of immature teratomas
- also associated with mature teratomas, mixed germ cell tumors, and ventriculoperitoneal shunts
- more common in younger patients
- should only contain mature glial elements, not any non-glial teratomatous elements
-- IF immature neuroepithelial tissue present, is considered a metastatic immature teratoma (needs chemo)
- IHC: SOX2+, GFAP+ (cytoplasmic), S100 +/-. OCT4-
- Considered a WHO grade 0 lesion, no chemo needed even if associated with an immature teratoma
- has no prognostic importance
Gliomatosis peritonei

Struma ovarii
Rare teratoma made of thyroid tissue (which can produce secreting thyroid malignancies, ie papillary thyroid carcinoma)
- may be seen with mucinous cystadenoma, Brenner tumor, or carcinoid tumor
Micro: thyroid follicles with colloid
IHC: (+) thyroglobulin / TTF-1, EMA
- neg: SYN, CHR, sex cord-stromal markers (CD99, Inhibin, Calretinin, Melan-A)
Genes: BRAF mutations in malig but not b9 tumors
Px: can turn into papillary "thyroid-oid" cancer
Struma ovarii

Endometrial sinus (yolk sac) tumor
Germ cell tumor consisting of endodermal extraembryonic tissues such as secondary yolk sac and allantois, and occasionally endodermal somatic tissues such as liver, intestine, and mesenchyme
- Aggressive malignancy (same as in boys testes) of younger women (~20 yo) that grows quickly, can also be in sacro-coccygeal area
- assoc c immature teratoma
- inc AFP and B-hCG
- subtypes include: endoermal sinus, hepatoid, reticular, polyvesicular vitelline
Gross: yellow, friable sold mass, avg 15cm, usually c mixed gct features (aka b9 teratoma component)
Micro: >1/2 have Schiller-Duval bodies (look like glomeruli), have clearing around glandular structures
- all have hyaline globs (+ for PAS, a1at, AFP)
- can have AFP eosinophilic globules
IHC: (+) CKs, AFP, CD10, SALL4, glypican 3
- negative CD30 (vs other GCTs), OCT4
Genes: aneuploidy or tetraploidy
- abnormal cr 12 (typically i(12p))
Px: lethal if chemotx not given (usually already mets at dx)
*** Yolk sac tumor and Schiller Duval both have 12 letters in them!!! (for cr 12 abnormalities!!!) ***



Yolk sac tumor

Dysgerminoma


Dysgerminoma -- has central collagenous scar, same as seminoma in testis


Dysgerminoma
Female counterpart to male seminoma; MC malignant primitive germ cell tumor
- 1% germ cell tumors in females (though is the MCC malignant germ cell tumor), 30%+ in dudes??
- mets to opposite ovary and around peritoneum
- 85% unilat, solid nodular, hemorrage and necrosis
-- may develop if a gonadoblastoma not excised
Labs: inc hCG and LDH
- can look "tigeroid" from delicate cytoplasm smearing out on smear
Micro: sheets of uniform large vesicular cells c well defined borders and clear cytoplasm (from glycogen) forming a kind of "fried egg" appearance, and can also show perivascular cuffing
- separated by fibrous stroma c T-cell lymphocytes
- can have hCG+ syncytiotrophoblastic cells close to BVs
- syncytiotrophoblastic cells present in ~3% of these tumors
IHC: (+) OCT4, SALL-4, c-kit, CAM5.2, AE1-3, PLAP
- CK7, CK20, EMA, HMW keratin, CD30, vimentin
Genes: 12p not normal (in 4/5) - isochromosome or poylsomy
Tx: since usually occurs during reproductive yrs, fertility-sparing surgery is preferred
Px: 95% survival
- mix c endodermal sinustumor or embryonal ca worsens
Embryonal carcinoma
Rarely seen in pure form, usually part of mixed germ cell tumor
- IHC: (+) CD30, AFP, OCT4, D2-40, NANOG, SALL4, SOX2
- negative CD117, c-kit
Embryonal carcinoma

Choriocarcinoma
Rare, malig cancer that can present during preg
Gross: bulky hemorrhagic mass invading uterine wall
Micro: biphasic with syncytiotrophoblasts and cytotrophoblasts
- large prominent syncytiotrophoblastic cells
- assoc c calcifications if do not see tumor cells in lung
Px: "cannon ball" mets to lung or brain
- choriocarcinoma more aggressive if arises from ovary versus from the placenta
IHC: (+) hCG-B
Choriocarcinoma


Carcinoid Tumors
- can be a type of monodermal teratoma
- 3/20 c cystic teratoma or mucinous cancer in contralateral ovary
- 33% c carcinoid syndrome, c constipation from peptide YY
- micro: same as carcinoid anywhere, cords 2-3 cells thick and salt n peppa chromatin, can have lots of fibrous stroma
-- insular patter looks like appendix / sm bowel tumors
-- trabecular like stomach or rectal tumors
-- strumal
-- mucinous
- ihc: (+) CHR, SYN, NSE
- neg: Inhibin
- px: good if ovarian primary
Stromal (sex cord) tumors
- combined c germ cell tumors, are about 5% of all ovarian neoplasms
*** FIG TheSel = Fig thisl *** (fig c branches like stroma)
FOXL2, SF1, inhibin, and calretinin are sensitive and specific markers for sex cord and stromal tumors of the ovary
- FOXL2 hihgly specific for adult granulosa cell tumor of the ovary
- sex cord / stromal tumors assoc c trisomy 12
IHC: (+) Inhibin, melan-A, CD10, CD99, Calretinin, SF1, FOXL2
- neg: CK, EMA
Fibromas
B9, common after onset of puberty
- most are bigger than 6 cm
- rarely assoc c Gorlin syndrome (NBCCS) may be considered if bilateral in younger pts
FibroThecoma: fibroma + thecoma
- assoc c inc E
- gross: yellow 2/2 lipid content and bc able to produce estrogen
Cellular fibroma (10% of cases)
- looks like diffuse type of adult granulosa cell tumor
- densely cellular with little intercellular collagen
- bland spindled nuclei with up to 3 mits / 10 hpf
Meig syndrome assoc
Micro: dense spindle cells, possibly storiform
- no atypia
- can have edema and bands of hyaline
Tx: excision
Px: no recurrence
DDx: Krukenberg tumors may get misdiagnosed as fibromas if not properly sampled
- fibrosarcomas have uniformly high cellularity, whereas cellular fibromas have alternating regions of high and low cellularity
- granulosa cell tumor for cellular fibromas
Cellular fibroma, with fascicles of spindle cells (from Young, Arch Pathol Lab med vol 142 Dec 2018)


Ovarian fibroma

Fibrothecoma -- yellow 2/2 lipid content and bc able to produce estrogen
Fibrosarcoma
Granulosa cell tumor (GCT)
Usually occuring after onset of puberty (though can cause precocious puberty in kiddas), assoc c hyperestrogenism (secrete E), differentiation to follicular granulosa cells
- can have variety of patterns (diffuse, trabecular, insular)
- Divided into Adult Granulosa Cell Tumor (AGCT) and Juvenile GCT (JGCT)
-- adult type peaks at age 50-55 yrs, but can be seen at any age (even rarely in children)
Gross: 5-15 cm, 95% unilat, confined to ovary encapsulated, large, yellow, variably cystic, sometimes hemorrhagic
- important to document whether has ruptured (may do so before surgery), has inc risk of recurrence
Micro: adult type can have many patterns
- small bland cuboidal cells c Call-Exner bodies (small follicle-like structures c acidophilic material)
- cells can be luteinized (esp in preggos, big nuclei c lots of cytoplasm), have coffee-bean shape (nuclear grooves), have focal hepatic differentiation, bile pigment?
- endometrium can have varying degrees of hyperplasia in 1/4 patients, due to inc Estrogen
Cyto: scant cytoplasm, irregular nuclear mem
IHC: (+) inhibin-a, vimentin, calretinin, CD99, SMA, desmoplakin, CD56, S100 (1/2), FOXL2 (highly specific)
- negative EMA, SYN/CHR (var), TTF-1, thyroglobulin, CD10
- Reticulin is the best to differentiate a thecoma from a granulosa cell tumor, where it is positive around each individual cell in a thecoma and around groups of cells in granulosa cell tumor
Genes: mono 22 (1/2), tri 12 (1/3), +14 (1/3)
- FOXL2 on cr 3
Tx: unilateral salpingo-oophorectomy
Px: low-grade malignancy (can recur years later), good, but cant tell if will turn malig from histology;
- depends on stage, tumor rupture, size and nuclear atypia
Granulosa Cell tumor
Call-Exner bodies circled

Granulosa cell tumor - reticulin
Typical trabeculated pattern, GCT

granulosa cell tumor, coffee bean shape

Juvenile Granulosa Cell Tumor
JGCT is a rare ovarian tumor and accounts for 5% of granulosa cell tumors. JGCT typically occurs in patients under 30 years old (97%), with a mean age of 13 years. JGCT may very rarely be seen in older patients.
- Prepubertal patients may present with precocious pseudo-puberty due to estrogen production, while postpubertal patients may present with menstrual irregularities.
- Most patients present with nonspecific abdominal pain and swelling due to mass effect
Irregular macrofollicles, lots of mits, large round nuclei, no nuclear grooves, abundant leuteinized cytoplasm, pleomorphism and atypia
Micro: Cystically dilated irregular immature follicles
- rare call exner bodies or nuclear grooving
- defining feature is the immaturity of the nuclei (vs AGCT)
- 10-15% have marked pleomorphism
- Unusual histologic features in JGCT include foci of marked atypia, prominent mitotic activity, and necrosis; however, these features do not portend a worse prognosis
Genes: AKT1 activating mutations can be seen in 60% of JGCT, and GNAS activating mutations can be seen in 30% of JGCT.
- Some patients may have somatic IDH1 and IDH2 mutations in association with Maffucci syndrome or Ollier disease
Px: JGCT limited to the ovary have an excellent prognosis following surgical removal, with a greater than 90% five-year survival rate.
- Extraovarian involvement (including positive cytology) and rupture are risk factors for recurrence.
Juvenile granulosa cell tumor

Juvenile granulosa cell tumor

JGCT

Thecoma
Mostly B9, hormonally active (E or androgens [granuloa cell tumor also an estrogenic neoplasm]) in older usually postmenopause women
- unilateral, firm and circumscribed by ovarian serosa
Micro: pale spindle cells without definite cell borders c liquid droplets and central nuclei
- hyaline plaques and collagen in stroma
- can have lots of calcium
IHC: (+) Oil red O, silver stains
- Reticulin is the best to differentiate from granulosa cell tumor, where it is positive around each individual cell in a thecoma and around groups of cells in granulosa cell tumor
Genes: trisomy 12
Thecoma with ill-defined cytoplasmic membranes and pale gray cytoplasm

Thecoma, low mag, with classic hyaline plaques


Thecoma - reticulin stain

Sertoli-Leydig tumor
rare, young (25 yo) women, 1/2 get virilization, almost always unilat and low stage c low (1/20) recurrence
- can show Sertoli cell and rete testis differentiation, but not have SDR-Y
Gross: yellow (like granulosa cell tumors) except that they have blood filled cysts
Micro: several different classifications based on the degree of tubular or lobular architecture
Meyer type I: well differentiated, 1/10 tumors, can be nodular or tubular, should be able to recognize Sertoli and Leydig cells c in tubular pattern, 1/5 have crystals of Reinke, can look like endometrioid ca
Meyer type II: intermed diff; 1/2 of tumors, may look like sarcoma, can have other histologic elements (sk muscle, cartilage), immature Sertoli and Leydig cells
Meyer type III: 66% have Leydig cells, can also have other histo elements
Teratoid androblastoma: has histo elements from different germ cell layers
Retiform variant: Usually poor-diff, can also have different histo elements, main feature is irreg branching c papillary structures
- can look like yolk-sac tumor (c Schiller-Duval bodies and (+) AFP
IHC: (+) T, E, CK, AFP (if it looks like liver), CD99, a-inhibin, PR, vimentin
- negative EMA, PLAP, CEA, CA19-9, CA125, S100
Genes: mutations in DICER, encoding RNase III endoribonuclease, have been identified, and pts c this mutation are at inc risk of getting this tumor
- DICER1 mutation may be assoc c thyroid dz, embetonal rhabdomosarcoma of cervix, and pleuropulmonary blastoma
SLCT can be divided into three molecular subtypes:
1) DICER1-mutant (approximately 50% of cases; associated with younger patients, moderately/poorly differentiated tumors, and retiform or heterologous elements);
2) FOXL2-mutant (moderately/poorly differentiated tumors often seen in older postmenopausal patients); and
3) DICER1/FOXL2-wildtype (welldifferentiated tumors).
Sertoli-Leydig tumor



Sertoli-Leidig tumor
Well-differentiated Sertoli-Leydig tumor with numerous hollow tubules separated by stroma with focal Leydig cells

Tubular anroblastoma - pure Sertoli cell


Sertoli cell tumor with large nested pattern
Tubular androblastoma (pure Sertoli cell tumor)
No Leydig cells or primitive stromal stuff, but is otherwise similar
- unilat, excess E sx
- excellent px, but can be more malig c lots of mits
- assoc c Peutz-Jeghers
Folliculoma lipidique: variant large Sertoli cells and c lots of lipid in the cytoplasm, assoc c isosexual pseudoprecocity
IHC: (+) inhibin, vimentin, CD99, CD10, AE1-3, CAM5.2
- negative EMA and chromogranin
Tx: excise
Gonadoblastoma
Mix of germ cell tumor and sex cord stromal tumor, usually found in pts c abnormal / indeterminate gonads (mixed gonadal dysgenesis) with some kind of Y chromosome involvement
- assoc c ataxia-telangiectasia
- 1/2 have dysgerminoma at the same time, often seen in context of mixed gonadal dysgenesis (kid born with 2 types of gonads)
- 1/3 bilateral
- >9/10 assoc c Turner syndrome (dysgenetic gonad)
Micro: primitive germ cells and sex cord stromal cells in nests separated by ovarian-type, fibrous stroma
- primitive germ cells are intermixed with Sertoli and granuilosa cells
- can see lots of calcification and hyalinization
- rare mits
IHC: (+) anti-Mullerian hormone focally, SALL4 and SF1
Genes: sometimes a c-KIT mutations
Tx: surgical steel (excise) - can turn malig if not excised
Px: super if completely excised
- can turn malignant dysgerminoma if not excised
Gynandroblastoma
Very rare, has granulosa cell (gyn) and Sertoli cell (andro) parts, each ~10% of the overall tumor volume
- heterologous elements are not uncommon
- usually present c stage 1 dz
Have both male and female sex cord elements present
Micro: small-med hollow tubes and trabecular cords
- can have oblond columnar nuclei and resemble Sertoli cells
- diffuse prolif of monotonous spindle cells and can have nuclear grooves and Call-Exner bodies

Gonadoblastoma

Gynandroblastoma

Small cell carcinoma of the ovary, hypercalcemic type (SCCOHT)
- undifferentiated neoplasm consisting of small monomorphic cells with a variable follicular-like component. A large cell component may occasionally be present.
- The tumor is often associated with paraneoplastic hypercalcemia, although many present with nonspecific abdominal distension and pain.
- Patients almost exclusively present during their reproductive years, with a mean age of 25 years old.
Micro: small cells with brisk mitotic activity, arranged in sheets, nests, trabeculae, or cords, with follicle-like spaces with eosinophilic to basophilic secretions.
- Necrosis is common.
- Some have a large cell component with abundant eosinophilic cytoplasm, large vesicular nuclei, and prominent nucleoli.
- Occasionally, rhabdoid morphology or a mucinous component may be present.
IHC: (+) WT1 and p53 (strong and diffuse)
- variable expression of calretinin, CD10, neuroendocrine markers, keratins, and EMA
Genes: vast majority of patients will have an inactivating somatic or germline SMARCA4 mutation that will manifest as a loss of expression of SMARCA4 (BRG1) by immunohistochemistry.
Px: poor
Pulmonary-type Small Cell Carcinoma
Middle-aged women (avg 60 yo) that looks like pulmonary small cell ca
- arises from immature teratoma
Micro: sheets / nests of cells c dark nuclei, fine chromatin, no nucleoli, scant cytoplasm
- prominent crush artifact
- Azzopardi effect: presence of necrotic DNA in venules
IHC: (+) cytokeratins, EMA, NSE, chromogranin (sometimes)
- vimentin
Genes: SMARCA4 gene mutation (also seen in ATRT)
Px: poor
Pulmonary-type small cell carcinoma


SCTAT
SCTAT

Sex cord tumor with annular tubules (SCTAT)
Assoc c hyperestrinism; 1/3 are assoc c Peutz-Jegher syndrome
- derived from follicular granulosa cells in ovarian cortex
Micro: mix of simple and complex annular tubules c eosinophilic hyaline bodies, usually calcified
- looks like Sertoli growth pattern in granulosa cell tumor
- complex annular tubules made of rings around hyaline bodies
DDx: gonadoblastoma, Granulosa cell tumor, Sertoli cell tumor
Microcystic Stromal Tumor (MCST)
Very rare and (somewhat) recently described ovarian tumor that has similarities with solid-pseudopapillary neoplasm of the pancreas
IHC: (+) B-catenin, CD10
Genes: B-catenin mutations
Microcystic stromal tumor

MCST, CD10

Sclerosing stromal tumor

Sclerosing stromal tumor with pseudolobulation and prominent blood vessels

Sclerosing Stromal Tumor
B9 sex cord stromal tumor, usually in young women, found incidentally
- may be assoc c estrogen or androgen production
Micro: lobular (pseudolobular) prolif of cellular nodules separated by collagenous stroma
- cells vary from spindled to round (can have inc cytoplasm and luteinization)
- commonly see prominent vessels with staghorn architecture
Genes: Sclerosing stromal tumors show recurrent
FHL2::GLI2 fusions in approximately 65% of cases, and other GLI2 rearrangements
in an additional 15%
DDx: other sex cord stromal tumors, thecomas, fibromas, SFT would be very rare in the ovaries, sometimes looks like hemangiopericytoma because of ectatic vessels
Female Adnexal Tumor of Wolffian Origin (FATWO)
Tumor restricted to the broad ligament
(+) PanCK, vimentin, calretinin
- EMA negative
FATWO

Salpinx
Adnexal Papillary Cystadenoma of Probable Mesonephric Origin (APMO)
All are assoc c vHL so far
- female version of epididymal papillary cystadenoma
Andenomatoid tumor of salpinges
MC b9 tumor of salpinx
- a-sx, unilat, well-circumscribed, gray-white, up to 2-3 cm
older women
- possible etiology: infoldings of visceral mesothelium
- NOT assoc c tubal ectopic preg
Micro: irregular tubular spaces of multiple sizes made of flat endothelioid cells, cytoplasmic vacuoles, clusters of cells; occasional big cells c red cytoplasm, sm muscle hyperplasia,
- rare mits, not much atypia
IHC: (+) calret, WT1, thrombomodulin, CKAE1/3, CAM5.2, CK7/8/18/19, ER/PR (in 4/5)
- negative: CEA,BER-EP4, CK5/6, EMA, vimentin, desmin, CD31/34, S100
Chlamydia
Follicular salpingitis
fused delicate epithelial folds c lots of cystic spaces, which can inc chance of tubal ectopic preg
IUD changes
Salpingitis Isthmica Nodosa
herniation of fallopian tube epithelium into wall, which can cause obstruction of tube and is assoc c endosalpingiosis and infertility and ectopic pregnancy
- younger adult black women; bilat
- nicely defined nodules close to isthmus, which may be hard to visualize
Micro: glands with b9 epithelium in sm muscle surrounded by minimal fibrous rxn
- glands can be dilated and perforate to lumen of the tubules
Tubal Intraepithelial Carcinoma (ITC)
IHC: (+) p53, high Ki67
- neg:
- vs stratified b9 tubal epithelium (has rare weak p53 positivity and low Ki67)
Serous Tubal Intraepithelial Carcinoma In Situ (STIC)
p53 can be strong and diffuse (>75%) or completely absent, will also have (+) p16 and high Ki67
- normal salpinx will have low Ki67 and wild-type p53
STIL is the precursor lesion
SCOUT has cellular outgrowth and has PAX2 loss
Adenocarcinoma of the Fallopian tube
Need to exclude direct extension of endometrium
Adenomatoid tumor of the fallopian tube



